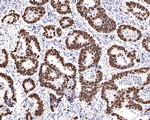
Ki-67 Antibody in Immunohistochemistry (Paraffin) (IHC (P))

Search
Invitrogen
Ki-67 Recombinant Rabbit Monoclonal Antibody (SR00-02)
{{$productOrderCtrl.translations['antibody.pdp.commerceCard.promotion.promotions']}}
{{$productOrderCtrl.translations['antibody.pdp.commerceCard.promotion.viewpromo']}}
{{$productOrderCtrl.translations['antibody.pdp.commerceCard.promotion.promocode']}}: {{promo.promoCode}} {{promo.promoTitle}} {{promo.promoDescription}}. {{$productOrderCtrl.translations['antibody.pdp.commerceCard.promotion.learnmore']}}
图: 1 / 12
Ki-67 Antibody (MA5-44693) in ICC/IF

Please note: We are reviewing Western blot images included in the antibody testing data in our catalog, including those provided by third parties. Unless expressly labeled or annotated as “raw-unedited”, Western blot images included in the antibody testing data in our catalog may have been edited, optimized or otherwise adjusted for presentation.
产品信息
MA5-44693
种属反应
宿主/亚型
Expression System
分类
类型
克隆号
抗原
偶联物
形式
浓度
规格
纯化类型
保存液
内含物
保存条件
运输条件
RRID
产品详细信息
Not suitable for Mouse in Immunofluorescence.
靶标信息
Ki-67 is a nuclear protein that is expressed during various stages in the cell cycle, particularly during late G1, S, G2, and M phases. The protein has a forkhead associated domain (FHA) through which it associates with euchromatin at the perichromosomal layer, the centromeric heterochromatin, and the nucleolus. Ki-67 is shown to have a cell cycle dependent topographical distribution with perinucleolar expression at G1, expression in the nuclear matrix at G2, and expression on the chromosomes during M phase. Ki-67 is commonly used as a proliferation marker because it is not detected in G0 cells, but increases steadily from G1 through mitosis. Ki-67 antibodies are useful in establishing the cell growing fraction in neoplasms. In neoplastic tissues, the prognostic value is comparable to the tritiated thymidine-labelling index. The correlation between low Ki-67 index and histologically low-grade tumors is strong. Ki-67 is routinely used as a neuronal marker of cell cycling and proliferation.
仅用于科研。不用于诊断过程。未经明确授权不得转售。
篇参考文献 (0)
生物信息学
蛋白别名: Antigen identified by monoclonal antibody Ki-67; Antigen identified by monoclonal antibody Ki-67 homolog; Antigen KI-67; Antigen KI-67 homolog; Proliferation marker protein Ki-67; RP11-380J17.2
基因别名: D630048A14Rik; Ki-67; Ki67; MKI67
UniProt ID: (Mouse) E9PVX6
Entrez Gene ID: (Rat) 291234, (Mouse) 17345




